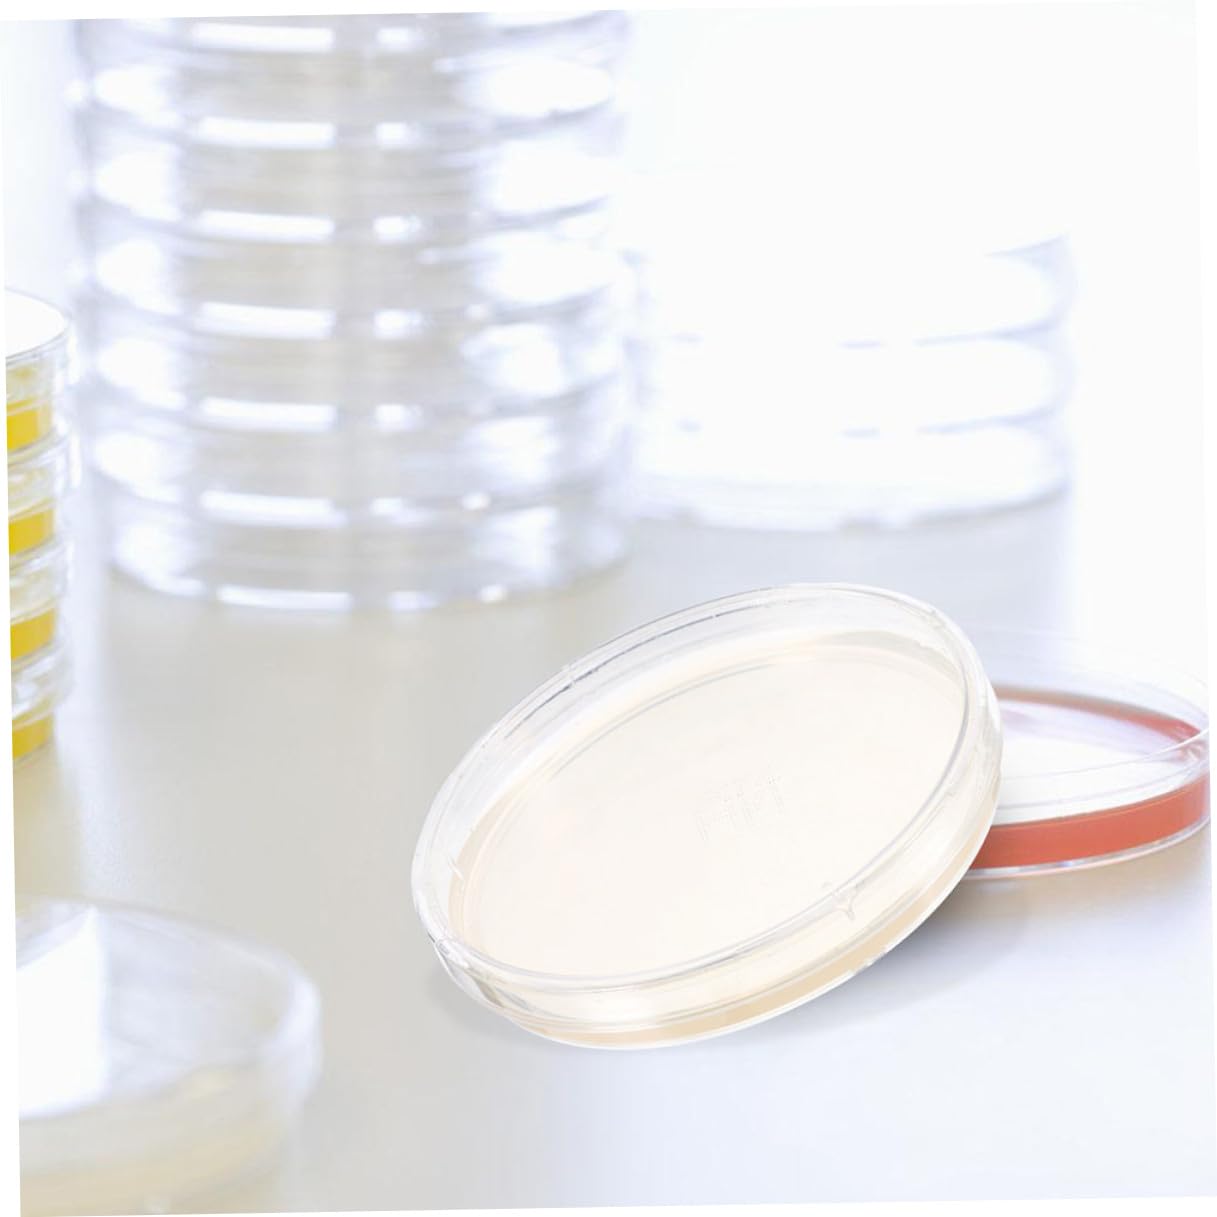

Cabilock 10pcs Nutrient Agar Petri Dishes 6cm Pre-Poured Agar Plates for Laboratory Use Microbiology Experiment Supplies
 Limited Time Sale
Limited Time Sale$54.00 cheaper than the new price!!
Free cash-on-delivery fees for purchases over $99
Product details
| Management number | 211014082 | Release Date | 2026/04/04 | List Price | $36.00 | Model Number | 211014082 | ||
|---|---|---|---|---|---|---|---|---|---|
| Category | |||||||||
Package List 10 x Nutritional Agar Plates Characteristics -Convenient design: the plate format is easy to handle and use, making it suitable for a variety of laboratory tasks and research activities microbiology kit -Color:Multi -Material:Agar -Nutrient-dense: with vital nutrients to support the cultivation , ensuring growth and development in laboratory settings industrial application plates -Size:6.00X6.00X2.00cm/2.36X2.36X0.79in -Highly reliable: subjected to stringent quality control and testing to ensure the product's accuracy and dependability, providing confidence in your experimental work lab themed parties -Wide range of uses: ideal for culture, screening, and various laboratory studies, flexibility for different scientific purposes agar plates for laboratory -Durable quality: produced using durable materials to maintain consistent and reliable quality, delivering dependable results in your scientific experiments -Product Info: Nutrient agar platesGoods Informationagar plates Whether used in research labs, educational settings, or industrial environments, these plates offer consistent results and are a reliable choice for cultivating specimens.industrial application plates The nutrient agar medium in these culture plates supports the growth of a wide range , making them versatile for various scientific experiments
- Easy to use: designed in a convenient plate shape, making it easy to carry and use in various laboratory settings and research projects,science experiment plates,science experiments
- Nutrient-dense: with vital nutrients to support the cultivation , ensuring growth and development in laboratory settings,agar petri plates,school science projects
- Nutrient-packed: contains an abundance of nutrients making it for various laboratory experiments,specimen dishes,petri agar plates
- Easy to use: the plate design is convenient for handling and use, making it an for both professional and educational laboratory environments,industrial application plates,plates for laboratory use
- Trustworthy: subjected to strict quality control and testing to ensure the product's accuracy and dependability, making it a reliable tool for your experimental needs,science plates,culture plate
| Item Weight | 10.6 ounces |
|---|---|
| Manufacturer | Cabilock |
| Item model number | 373N5420K3U2TM58ZV |
| Product Dimensions | 2.36 x 2.36 x 0.79 inches |
Correction of product information
If you notice any omissions or errors in the product information on this page, please use the correction request form below.
Correction Request Form